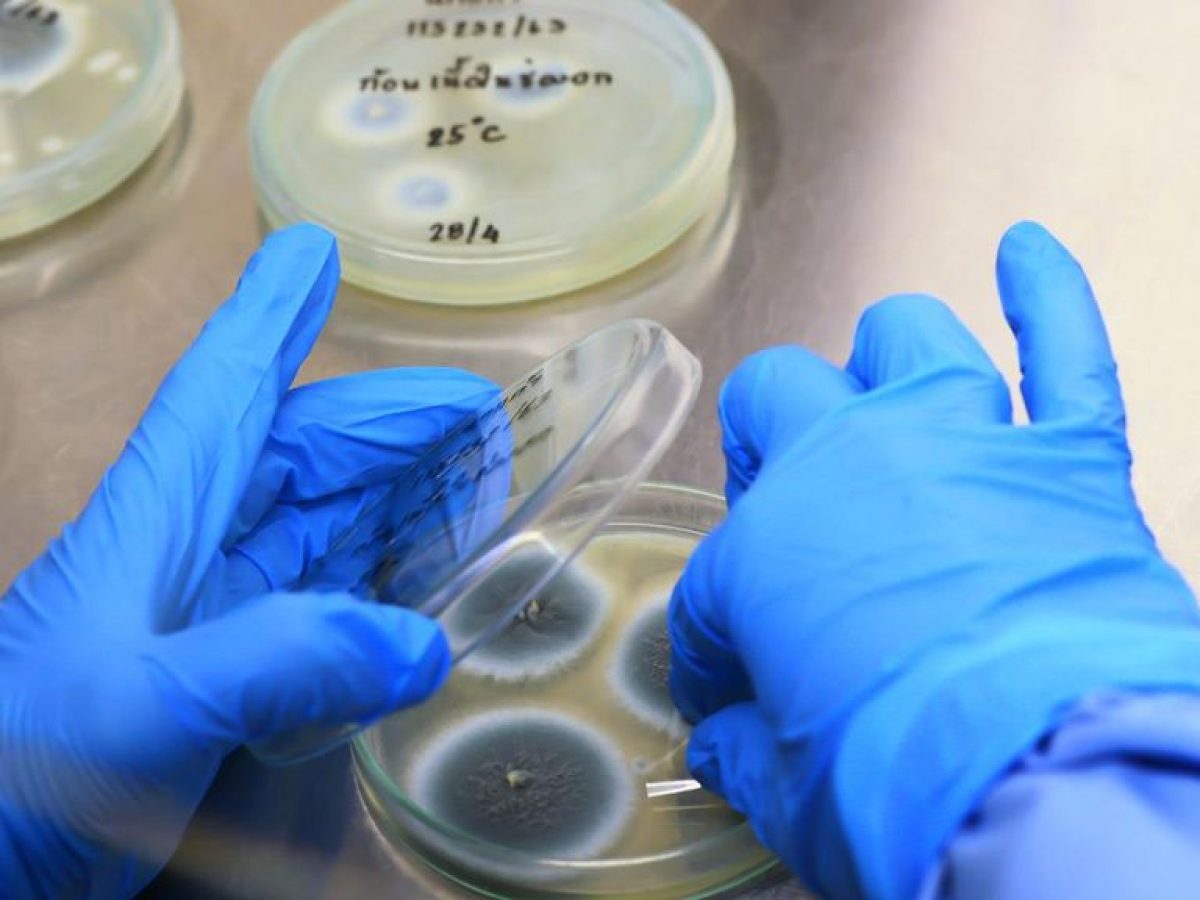

Η μικροβιολόγος Michaela Lackner από το Ίνσμπρουκ προειδοποιεί για την αυξανόμενη αντοχή των μυκήτων στα φάρμακα της κατηγορίας των αζολών, που αποτελούν βασικό όπλο κατά των σοβαρών μυκητιασικών λοιμώξεων.Αντλίες ιόντων και “χημικά ψαλίδια” επιτρέπουν την ακριβή χορήγηση φαρμάκων
Ο συνδυασμός λοιμώξεων που αυξάνει τον κίνδυνο πολλαπλής σκλήρυνσης [μελέτη]
11ο Οικονομικό Φόρουμ των Δελφών: Ανάλυση των προκλήσεων της νέας εποχής
Το πρωτότυπο άρθρο ανήκει στο iatronet.gr υγεία διατροφή ομορφιά φυσική κατάσταση ειδήσεις .